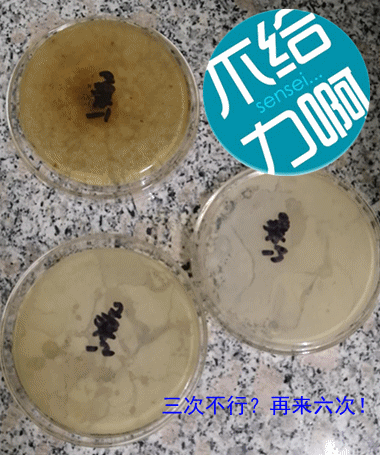

德州健之源生物科技有限公司
電 話:400-655-8043
Email:dzjzyswkj@163.com
電 話:400-655-8043
Email:dzjzyswkj@163.com
網 址:m.jxfloor.com
桑葉是我國重要的傳統中藥之一,具有降血壓、降血糖、降血脂、抗疲勞、增強免疫、抗衰老等功效。德州健之源生物科技有限公司將桑葉加工制成具有保健功能的“故道桑業”袋裝桑葉茶,是具有降三高、美膚、減肥等作用的保健佳品,并將桑葉多元化利用推向新的高度。
每一個新產品的推出,都凝聚著公司研發人員的心血和汗水,在德州健之源“故道桑業”袋泡茶問世之際,請讓我們將最崇高的敬意和最熱烈的掌聲獻給他們,感謝他們的付出和努力!
感覺一切語言都顯的那么空洞和無力,還是讓我們隨著鏡頭來看看“小寶貝”的誕生記吧-----